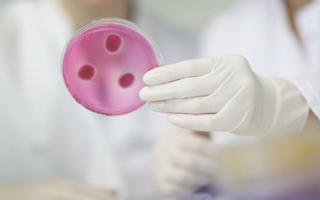
Untersuchung-der.jpg

Research
Gemeinsam haben die Preisträger ein neuartiges Konzept für kostengünstige, flexible und intuitiv bedienbare Roboter geschaffen © Stifterverband für die Deutsche Wissenschaft
30/11/2017 – Stifterverband für die Deutsche Wissenschaft
Stifterverband für die Deutsche Wissenschaft
Der symbolische Spatenstich zum Bau einer Faserpilotanlage in Bayreuth fand heute unter Teilnahme von Bayerns Wirtschaftsministerin Ilse Aigner und vielen anderen Ehrengästen statt © BJS Ceramics GmbH
23/11/2017 – BJS Ceramics GmbH
BJS Ceramics GmbH
Im Rahmen seines zweitägigen Antrittsbesuchs in Sachsen war Bundespräsident Frank-Walter Steinmeier am 14. November 2017 an der TU Dresden zu Gast. Gemeinsam mit seiner Frau Elke Büdenbender informierte er sich vor Ort über den prämierten Zukunftswerkstoff Carbonbeton. Im Bild rechts Professor Chokri Cherif © TU Dresden / Sven Hofmann